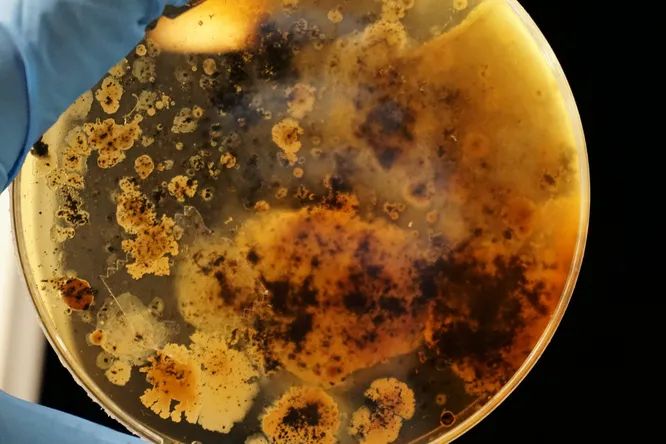
Ученые обнаружили «таинственные» бактерии в метро разных городов мира

Ученые обнаружили «таинственные» бактерии в метро разных городов мира
Международная группа исследователей обнаружила, что в метрополитене обитают тысячи таинственных вирусов и бактерий! Проанализированные образцы также содержали микроорганизмы, которые являются причиной неприятного запаха кожи и прыщей.
Каждый день в метро спускаются сотни тысяч людей! Это место — настоящий рай для микробной жизни
В рамках новой работы около 900 ученых и волонтеров собирали микробные образцы с перил, турникетов, сидений и билетных касс в метро по всему миру на разных континентах. Анализ показал, что каждый мегаполис имеет свой собственный «микробный отпечаток». Состав образцов был обусловлен климатическими и географическими различиями. Многие бактерии и микробы были очень типичны для определенных регионов.
Из 4000 образцов ученые обнаружили 4246 известных видов микробов, около 70% из которых были бактериями. Из них 31 вид присутствовал почти в каждом городе, образуя «ядро городского микробиома». Например, Micrococcus luteus — бактерия, ответственная за запах тела, и Cutibacterium acnes — вид, связанный с развитием акне.
Однако не все микробы были идентифицированы, как отмечают авторы проекта, около 45% , включая около 11 000 вирусов и 700 бактерий, не соответствовали ни одному известному виду. «Это действительно микроорганизмы, но их нет ни в одной базе данных», — сказала биолог Даниэла Бездан, один из соавторов проекта.
Однако ученые не видят причин для беспокойства, напротив, они уверены, что неизвестные бактерии могут иметь потенциал для изготовления новых лекарств, а более детальный мониторинг городских микробиомов может привести к раннему обнаружению патогенов и потенциально предотвратить еще одну пандемию.
«Мы не видим ничего, о чем стоит беспокоиться», — сказал автор исследования Дэвид Данко. «Мы не хотим, чтобы люди боялись этих микробов, потому что это всего лишь часть экосистемы, в которой мы, люди, живем».
Comments are closed.